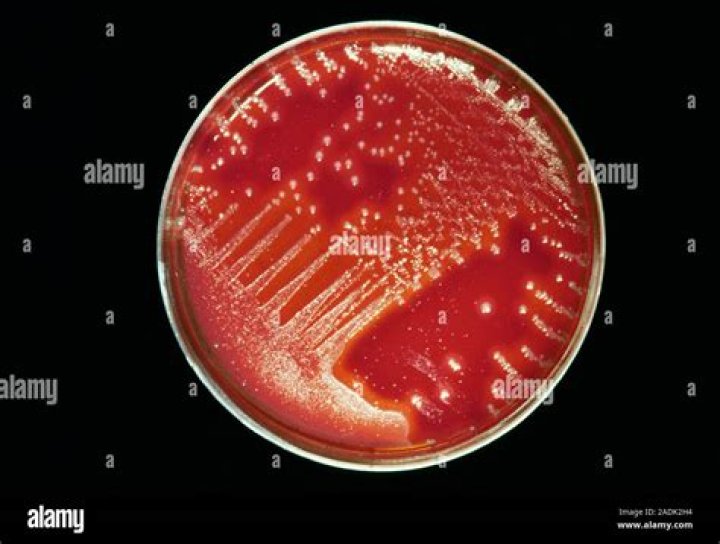

Inspectors normally work 40-hour weeks; however, they may work additional hours during periods of increased construction or if an accident occurs at a construction site.
How many hours does an inspector work?
Overtime Details Typically, in a career as food inspector, they are required to work for 9 hours per day.
Is being a home inspector hard?
Getting your home inspection certification requires a lot of education, testing, and hands on training. This is not to say that the process is difficult – it will simply take time and hard work to do it right.
Do home inspectors stay busy?
In fact, many people who have non-traditional schedules like firefighters or paramedics will start a home inspection business in addition to their first career to keep themselves busy and bring in extra revenue.Whats it like being a home inspector?
A typical home inspector spends his or her day in a wide-range of activities like inspecting homes for buyers, writing reports, speaking with prospective clients, and marketing to consumers and real estate agents. You should expect long days, long drives, physical demands, and that you will make mistakes.
Is food inspector a good career?
Out of all a Food Inspector Career tops the charts – both in terms of Job Availability & Future Scope. A career in food inspection is where you can find that ideal endeavor of job advancement potential and sense of ensuring the safety of the community.
Is food inspector exam easy?
Food Inspector is one of the competitive exams. It is not going to be an easy task to crack it then let it be state level or national level. Simultaneously many candidates also apply for vacancies. So, if you want to come out with flying colors in this competitive exam you should start your preparation early.
Should I tip my home inspector?
Home Inspector: Tips? No, not for home inspectors. They perform a vital role for new homebuyers, but they are already compensated well for their services.Are home inspections worth the money?
It also depends on the type of property and we will always recommend a home inspection whether you’re buying a single-family home or a condo, they are worth the peace of mind in our opinion! … If you need to leave during the home inspection, or you can’t be there for it, the inspector can still examine the home.
Can Home Inspectors lie?Finding a home you want to buy can feel magical. … provided the home inspection doesn’t uncover any problems. But just like a magician, some sellers have a few tricks up their sleeves. It’s not that they plan to lie, although there are always people who tweak the truth.
Article first time published onWhat type of inspector makes the most money?
Inspector salaries can vary on many factors, including what industry a job is in. In fact, jobs with Technology, Automotive, and Manufacturing companies tend to be the highest paying.
How do I market myself as a home inspector?
- Have a Home Inspection Website, and Ensure it’s Mobile Friendly. …
- Get a Logo. …
- Set Up a Google My Business Site. …
- Marketing Your Inspection Business on Social Media. …
- Business Cards and Flyers for Marketing. …
- Get Reviews for Your Home Inspection Business. …
- Work With Local Realtors.
What does a property inspector do?
Property inspectors evaluate residential properties for compliance in regulations. They perform thorough property inspections, interview homeowners, and prepare inspection reports. They may work for local government, or be employed in real estate, construction, banking, or insurance.
How can I be a good inspector?
- English language ability. …
- Logic and attention to detail. …
- Effective communication skills. …
- Integrity. …
- Technical ability.
How much does a home inspector make in California?
The average salary for a home inspector is $56,483 per year in California and $35,000 commission per year.
How long does it take to become a home inspector in Florida?
The Florida Department of Business and Professional Regulation (DBPR website for home inspectors) requires individuals to complete 120 hours of state-approved training, pass a state exam, and submit an application to the state.
Which degree is best for food inspector?
To be eligible to become a Food Inspector the aspiring candidate must have a Bachelor’s degree in any stream. However, Bachelor’s degree in related subjects like biology, math, physics, or agricultural sciences can be of added advantage.
What qualifications do I need to be a food inspector?
A degree in Food Technology, a diploma in Environmental Health and/or a Higher Certificate in Food Premises Inspection may be required. An understanding of HACCP, and a qualification, is often also specified.
How can I become a drug inspector?
- The first step in becoming a drug inspector is to get a bachelor’s degree in Pharmacy. …
- The second step would be getting a master’s degree in Pharmacy. …
- The next step would be appearing in the entrance exams conducted by the UPSC and various SPSCs when there are vacancies.
Where do food inspectors typically work?
Food inspectors work in a variety of settings. In this field, you may work in a slaughterhouse, farm, egg processing plant, or any other food production facility. You may be required to travel between facilities and be responsible for many different sites.
What kind of job is a food inspector?
A food inspector is a public health professional who ensures that meat, poultry and other related food products processed in private plants meet safety and labeling requirements. They may also inspect restaurants and supermarkets for sanitation compliance, food storage practices and food handling compliance.
Is Drug inspector exam difficult?
Nothing is easy but if you really want it to happen and put your all efforts in it you’ll definitely achieve the same. The qualities required are disciplined, patient, commitment, knowledgeable, capacity to perform tests, evaluation, up to date with recent developments in pharmaceutical field.
What are home inspectors not allowed to do?
The home inspector has a responsibility to perform a non-invasive, visual examination. This means the home inspector can only examine the readily accessible areas of the home. A home inspector is not allowed to perform destructive measures such as removing drywall, siding, trim, paneling, floor coverings, etc.
Do home Inspectors try to find something wrong?
An inspector will be looking for problems with the home’s heating and cooling systems, electrical problems, signs of water damage, mold or leaks, termites, and structural or plumbing problems.
Do home Inspectors exaggerate?
An exceptional home inspector will be as good at presenting information as they are at finding problems. The best inspectors don’t exaggerate issues to make buyers walk away from perfectly good homes.
Should I tip my Realtor as a buyer?
You should not tip your Realtor, in any way. It is neither expected or considered the standard practice. In fact, some real estate agents say that gifts or bonuses make them uncomfortable. Tips can actually cause them extra work to ensure they stay within the law and adhere to their licensing regulations.
Do you tip your buyers agent?
No. Gratuities are neither expected nor commonly given to a real estate agent. If you would like to reward your agent for doing an exceptional job, the best gift you can give is a testimonial, endorsement, referral or other promotional reference to his skills as a buyer’s agent.
What is a red flag on a home inspection?
Summary. A home inspection is meant to highlight potential issues that the property may have, whether they are visible or not. These assessments sometimes call attention to red flags, such as water damage, mold, and faulty electric and plumbing systems.
Do Home Inspectors look in closets?
Home inspectors need access to attics, crawl spaces, basements, closets, and circuit breakers. … Sometimes people like to hide a fuse box with shelving or other décor, but inspectors need to take the cover off to take a look inside.
What do home inspectors miss?
- Pests. Many a new buyer has signed paperwork and moved into a house only to discover that there’s a pest problem – termites, rodents, even snakes. …
- Lead Paint. …
- Toxic Mold. …
- Asbestos. …
- Radon Gas. …
- Swimming Pool Issues. …
- HVAC Problems. …
- Roof Leaks.
How much does a home inspector make in Los Angeles?
The average salary for a home inspector is $52,260 per year in Los Angeles, CA and $35,000 commission per year.